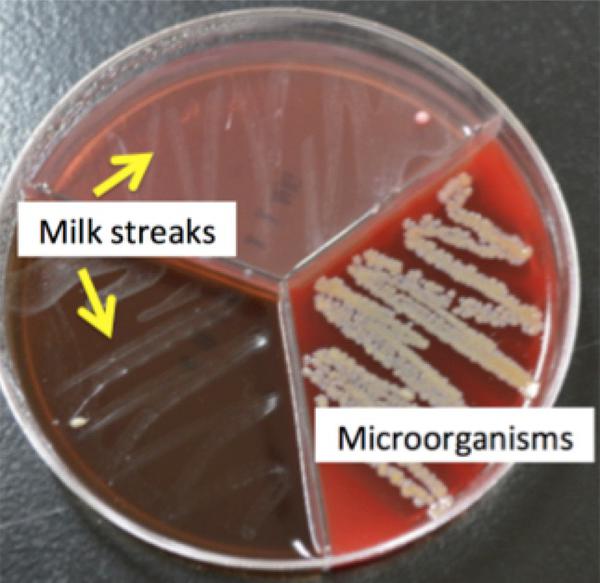

Characteristics of Oklahoma Agritourism Facebook Posts
Journal of Applied Communications, 2020

For class projects and research with Dr. Quisto Settle, I published additional academic articles.
Under the visionary leadership of Dr. Amanda Stone, I visited dairy farms across Mississippi each week. It was an experience I cherish greatly.